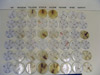
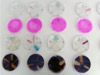

¿Quién es Biodyne Perú?
Biodyne Perú fue fundado en el año 2011. Somos el socio de negocios exclusivo para Perú de Biodyne World, ubicado en Sarasota, Florida EE. UU. Biodyne Perú es una compañía innovadora que trabaja en el uso de la microbiología aplicada como solución a muchos de los problemas frecuentes de nuestro medio ambiente. La palabra Biodyne significa "poder biológico". El enfoque del laboratorio consiste en aprovechar el "poder biológico" de los microorganismos para usarlos en procesos de biorremediación ambiental.
Biodyne Perú, como representante exclusivo para Perú de Biodyne World, cuenta con las instalaciones, el personal y la experiencia necesaria para producir y brindar soporte técnico a los productos microbiológicos que se usan en un amplio rango de aplicaciones ambientales.
Sabemos que el éxito de las inoculaciones depende en gran medida del soporte técnico. Por eso nuestra empresa cuenta con un grupo de profesionales idóneos en diferentes aéreas de la biología y el medio ambiente dispuestos a evaluar cada situación para que las aplicaciones se realicen de la mejor forma posible. Igualmente y cuando la situación lo requiere contamos con el apoyo del laboratorio principal en Estados Unidos.